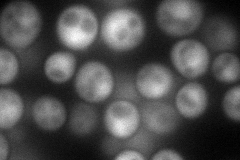
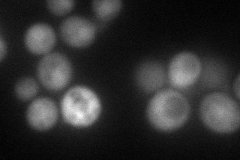
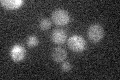

View description
Major isozyme of methylenetetrahydrofolate reductase, catalyzes the reduction of 5,10-methylenetetrahydrofolate to 5-methyltetrahydrofolate in the methionine biosynthesis pathway
Localization:
Intensity:
Fold change:
Significance:
-
C’ GFP library in SD

below threshold16.44 -
N' NOP1pr-GFP in SD
cytosol,nucleus113.929 -
N' TEF2pr-mCherry in SD
nucleus84.6664 -
N' NATIVEpr-GFP in SD

punctate19.5228 -
N' TEF2pr-VC and Cyto-VN in SD

#N/A0 -
C’ GFP library in SD+DTT

cytosol17.291.05No -
C’ GFP library in SD+H2O2

cytosol16.81.02No -
C’ GFP library in Starvation Media
cytosol15.390.93No -
C’ GFP library on the background of Pup2-DaMP

below threshold -
C’ GFP library on the background of CCT mutant

below threshold18.68821.13651No
